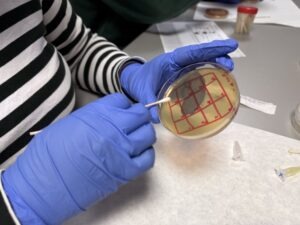
Micromundo
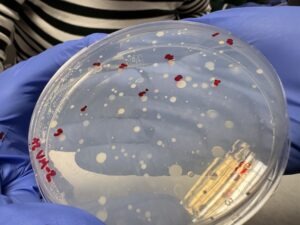
Micromundo

Bach: Micromundo
A lo largo de estas semanas los alumnos de primero de bachillerato del Colegio Virgen de Mirasierra participan en Micromundo, un proyecto de Aprendizaje y Servicio junto a la UCM.
Este curso el proyecto consiste en cultivar bacterias buscando resistencia a antibióticos.
Los alumnos están disfrutando con esta experiencia práctica que les está permitiendo aprender sobre el comportamiento de las bacterias en entornos preparados.